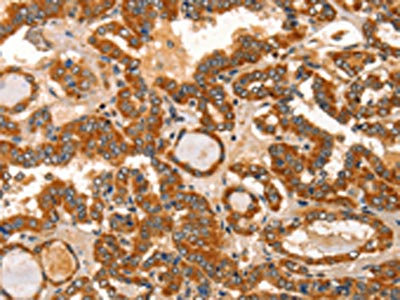

IKZF3 Antibody
-
中文名稱:IKZF3兔多克隆抗體
-
貨號:CSB-PA192244
-
規(guī)格:¥1100
-
圖片:
-
The image on the left is immunohistochemistry of paraffin-embedded Human liver cancer tissue using CSB-PA192244(IKZF3 Antibody) at dilution 1/60, on the right is treated with fusion protein. (Original magnification: ×200)
-
The image on the left is immunohistochemistry of paraffin-embedded Human thyroid cancer tissue using CSB-PA192244(IKZF3 Antibody) at dilution 1/60, on the right is treated with fusion protein. (Original magnification: ×200)
-
-
其他:
產(chǎn)品詳情
-
Uniprot No.:
-
基因名:
-
別名:AIO antibody; Aiolos antibody; IKAROS family zinc finger 3 (Aiolos) antibody; IKAROS family zinc finger 3 antibody; Ikaros family zinc finger protein 3 antibody; IKZF 3 antibody; IKZF3 antibody; IKZF3_HUMAN antibody; zinc finger DNA binding protein Aiolos antibody; Zinc finger protein Aiolos antibody; Zinc finger protein subfamily 1A 3 (Aiolos) antibody; Zinc finger protein subfamily 1A 3 antibody; Zinc finger protein subfamily 1A; member 3 antibody; ZNFN1A3 antibody
-
宿主:Rabbit
-
反應(yīng)種屬:Human,Mouse
-
免疫原:Fusion protein of Human IKZF3
-
免疫原種屬:Homo sapiens (Human)
-
標(biāo)記方式:Non-conjugated
-
抗體亞型:IgG
-
純化方式:Antigen affinity purification
-
濃度:It differs from different batches. Please contact us to confirm it.
-
保存緩沖液:-20°C, pH7.4 PBS, 0.05% NaN3, 40% Glycerol
-
產(chǎn)品提供形式:Liquid
-
應(yīng)用范圍:ELISA,IHC
-
推薦稀釋比:
Application Recommended Dilution ELISA 1:1000-1:5000 IHC 1:50-1:200 -
Protocols:
-
儲(chǔ)存條件:Upon receipt, store at -20°C or -80°C. Avoid repeated freeze.
-
貨期:Basically, we can dispatch the products out in 1-3 working days after receiving your orders. Delivery time maybe differs from different purchasing way or location, please kindly consult your local distributors for specific delivery time.
-
用途:For Research Use Only. Not for use in diagnostic or therapeutic procedures.
相關(guān)產(chǎn)品
靶點(diǎn)詳情
-
功能:Transcription factor that plays an important role in the regulation of lymphocyte differentiation. Plays an essential role in regulation of B-cell differentiation, proliferation and maturation to an effector state. Involved in regulating BCL2 expression and controlling apoptosis in T-cells in an IL2-dependent manner.
-
基因功能參考文獻(xiàn):
- The minor alleles of rs2941522, rs907091, rs1453559, rs12150079 and rs2872507 were statistically associated with an increased risk in Graves' disease patients. PMID: 29510406
- Aiolos promotes the binding of Blimp-1 to target genes and thereby enhances Blimp-1-dependent transcriptional repression. PMID: 26823144
- Our data indicate a possible regulatory role for the multiple sclerosis-associated IKZF3 and IQGAP1 variants. PMID: 27080863
- results indicate that overexpression of Aiolos may contribute to pathogenesis of SLE and RA PMID: 26546109
- Aiolos improved the survival of Nalm6 cells via PTEN and Aktdependent processes. PMID: 25608224
- NFKB1, CD27, LAG3 and IKZF3 are new susceptibility genes for psoriasis. PMID: 25006012
- lentivirus-mediated AIOLOS overexpression in Jurkat cells induced cell apoptosis, arrested the cell cycle at the G0/G1 phase, and synergistically increased the sensitivity of Jurkat cells to etoposide by inhibiting NF-kappaB activity. PMID: 25524659
- identified a unique case of adult acute B-cell lymphoblastic leukemia with masked low hypodiploidy (mLH) by genomic duplication PMID: 26185311
- The allele T of rs10852936 surrounding the IKZF3-ZPBP2 locus confers risk for early-onset psoriasis. PMID: 25620289
- A strong association between rs907091 in the IKZF3 gene and SLE was identified. PMID: 25271777
- The immunosuppressive enzyme IL4I1 expressed differentially in human induced Aiolos+, but not natural Helios+, FOXP3+ Treg cells. PMID: 25446972
- A strong allelic association between SNPs in the 17q21 region (IKZF3) and asthma has been confirmed for the Latinos population. PMID: 24406073
- Overexpression of AIOLOS inhibits cell proliferation, suppresses apoptosis and arrests the cell cycle at the G0/G1 phase in vitro. PMID: 24399134
- Aiolos reconfigures chromatin structure within the SHC1 gene, causing isoform-specific silencing of the anchorage reporter p66(Shc) and blocking anoikis in vitro and in vivo. PMID: 24823637
- Sixteen SNPs were significantly associated with asthma of which one SNP was novel (IKZF3-rs1453559). PMID: 22626592
- Four additional susceptibility loci (IRF8, TMEM39A, IKZF3, and ZPBP2) for systemic lupus erythematosus were robustly established a multiethnic population (European, African American, Asian, Hispanic, Gullah, and Amerindian). PMID: 22464253
- To determine the consequences of Aiolos deregulation in B-CLL, we analyzed the effects of Aiolos overexpression or down-regulation on apoptosis. PMID: 21139082
- distribution of positive and negative expression of Aiolos and Helios found in various types of leukemias could implicate common pathways of their regulation PMID: 20432734
- Aiolos knockout mice develop the symptoms of human systemic lupus erythematosus (SLE). This finding implicates Aiolos as a possible candidate gene for SLE. PMID: 12574333
- we show for the first time the differential Aiolos expression at the RNA and protein level in hematopoietic cell subpopulations. PMID: 19540588
- Short isoforms of Aiolos were detected at low levels in bone marrow of normal volunters, but were not overexpressed in a patient with acute T-cell leukemia. Data for unaltered Aiolos indicates tumor suppressor function. PMID: 11937265
- impairment of Aiolos activity in human leukemia is not based on deficient phosphorylation as had been demonstrated in experiments in vitro PMID: 17296582
- this work demonstrates that the cellular activities of Aiolos isoforms are dependent on combinations of various functional domains arising from the differential splicing of mRNA transcripts PMID: 17646674
- up-regulation of Aiolos, confirmed at protein level, seems independent of Aiolos promoter H3K9 acetylation and H3K4 trimethylation PMID: 18184862
- DNA methylation directs Aiolos silencing and chromatin status in tumor cell lines, while in primary cells is mainly regulated by histone modifications. PMID: 18206652
顯示更多
收起更多
-
亞細(xì)胞定位:Nucleus. Cytoplasm.
-
蛋白家族:Ikaros C2H2-type zinc-finger protein family
-
組織特異性:Expressed most strongly in peripheral blood leukocytes, the spleen, and the thymus.
-
數(shù)據(jù)庫鏈接:
Most popular with customers
-
-
YWHAB Recombinant Monoclonal Antibody
Applications: ELISA, WB, IHC, IF, FC
Species Reactivity: Human, Mouse, Rat
-
Phospho-YAP1 (S127) Recombinant Monoclonal Antibody
Applications: ELISA, WB, IHC
Species Reactivity: Human
-
-
-
-
-